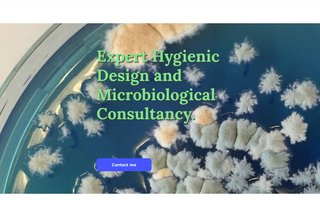

|
km-ejendomsservice.dk
|
K.M. Ejendomsservice
|
Ledøjetoften 11
|
2026-03-07 |
ok
|

|
egelundbyg-aps.dk
|
Henrik Kvistorf Egelund
|
Smørumnedre
|
2026-03-07 |
ok
|

|
glshorsecare.dk
|
GLS Foder ApS
|
Smørumovre
|
2026-03-07 |
ok
|

|
jcb-ejendomme.dk
|
JCB Gruppen ApS
|
Lille Smørum
|
2026-03-07 |
ok
|

|
nielsen2020.dk
|
Karl Vilhelm Nielsen
|
Smørumnedre
|
2026-03-07 |
ok
|

|
krystalsol.dk
|
Hanne Regel
|
Lille Smørum
|
2026-03-06 |
ok
|

|
egedalbogfest.dk
|
Rie Skovgaard Borgstrøm
|
Smørumvang
|
2026-03-06 |
ok
|

|
shoppingonline.dk
|
Getresults
|
Jordbærvangen 4
|
2026-03-06 |
ok
|

|
hovehus.dk
|
Jan Axel Christensen
|
Hove
|
2026-03-06 |
ok
|

|
keum.dk
|
Mia Keum Jørgensen
|
Smørumnedre
|
2026-03-06 |
ok
|

|
charlotteb.dk
|
Charlotte Christina Bruun
|
Smørumnedre
|
2026-03-06 |
ok
|

|
d2a.dk
|
Dan Jesper Andersen
|
Smørumnedre
|
2026-03-06 |
ok
|

|
petanque-ballerup.dk
|
Torben Petersen
|
Smørumvang
|
2026-03-06 |
ok
|

|
pv2net.dk
|
Sven Kruse Andersen
|
Dyvelåsen 20
|
2026-03-06 |
ok
|

|
e-lund.dk
|
Erik Lund
|
Søagerbakken 25
|
2026-03-06 |
ok
|

|
swredstrom.dk
|
Svenning Wredstrøm
|
Smørumnedre
|
2026-03-06 |
ok
|

|
vidconf.dk
|
Matthias Prahl Kristjánsson
|
Smørumnedre
|
2026-03-06 |
ok
|

|
ournature.dk
|
Mads Kabango Larsen
|
Smørumnedre
|
2026-03-06 |
ok
|

|
heste-godbidder.dk
|
GLS Foder ApS
|
Smørumovre
|
2026-03-06 |
ok
|

|
partyline.dk
|
PM-Dronefoto.dk
|
Rådhuslunden 1, a.
|
2026-03-05 |
ok
|

|
stoklund-larsen.dk
|
Birgitte Stoklund Larsen
|
Smørumnedre
|
2026-03-05 |
ok
|

|
i-tech.dk
|
ITECH
|
Smørumnedre
|
2026-03-05 |
ok
|
|
biopres.dk
|
Per Væggemose Nielsen
|
Smørumovre
|
2026-03-05 |
ok
|

|
treibhaus.dk
|
Treibhaus ApS
|
Hove Overdrev
|
2026-03-05 |
ok
|

|
henka.dk
|
HENKA A/S
|
Lille Smørum
|
2026-03-05 |
ok
|

|
annaholmnielsen.dk
|
2nd Level
|
Kong Knuds Park 43
|
2026-03-05 |
ok
|

|
janus-friis.dk
|
Janus Friis
|
Smørumnedre
|
2026-03-05 |
ok
|

|
zomaku.dk
|
Zomaku
|
Bakkevej 11
|
2026-03-05 |
ok
|

|
kefocom.dk
|
KEFOCOM
|
Hindbærvangen 75
|
2026-03-05 |
ok
|

|
wifstrand.dk
|
Svend Ole Poulsen
|
Smørumnedre
|
2026-03-05 |
ok
|

|
tmvinduespolering.dk
|
ITCura
|
Smørumnedre
|
2026-03-04 |
ok
|

|
hdel.dk
|
Poul Hahn Damgaard Henningsen
|
Smørumnedre
|
2026-03-04 |
ok
|

|
mmcite.dk
|
ELVERDALS PROF DANISH PRODUCTS A/S
|
Ledøje
|
2026-03-04 |
ok
|

|
bestfloor.dk
|
Bes't floors
|
Kirsebærvangen 184
|
2026-03-04 |
ok
|

|
hoygaard.dk
|
Lars Høygaard Michaelsen
|
Smørumnedre
|
2026-03-04 |
ok
|

|
better-now.dk
|
Carsten Lindkvist Madsen
|
Smørumnedre
|
2026-03-04 |
ok
|

|
flyttevognen.dk
|
PAWELCZUK TRANSPORT ApS
|
Smørumnedre
|
2026-03-03 |
ok
|

|
interoception.dk
|
Anna Katrin Ekström
|
Smørumnedre
|
2026-03-03 |
ok
|

|
andresen-marketing.dk
|
Wicki Andresen
|
Smørumnedre
|
2026-03-03 |
ok
|

|
lhch.dk
|
Lars Hougaard
|
Smørumnedre
|
2026-03-03 |
ok
|

|
hmw.dk
|
Henrik Monrad Winkel
|
Skindengen 5
|
2026-03-03 |
ok
|

|
groskopf.dk
|
GROSKOPF
|
Tulipanhaven 55
|
2026-03-03 |
ok
|

|
xn--kandehaven-05a.dk
|
MIKADO DATA
|
Smørumnedre
|
2026-03-03 |
ok
|

|
kroers.dk
|
Dennis Kroer
|
Smørumnedre
|
2026-03-03 |
ok
|
|
—
|
supreme-chins.dk
|
Maria Gratved
|
Smørumnedre
|
2026-03-03 |
err
|

|
danskeevent.dk
|
JOHANNSEN DEKORATION. ISHØJ A/S
|
Lille Smørum
|
2026-03-03 |
ok
|

|
gadgetstilham.dk
|
Allan Foldberg Iversen
|
Kong Knuds Park 3
|
2026-03-03 |
ok
|

|
vandbesparende.dk
|
KLAR INVEST ApS
|
Smørumnedre
|
2026-03-02 |
ok
|

|
taepperpaamaal.dk
|
JOHANNSEN DEKORATION. ISHØJ A/S
|
Lille Smørum
|
2026-03-02 |
ok
|

|
popgoesrock.dk
|
Nial Nordbjerg
|
Smørumnedre
|
2026-03-02 |
ok
|

|
xn--naturgdningkbh-vqb.dk
|
Gunner Larsen & Søn
|
Edelgavevej 5
|
2026-03-02 |
ok
|

|
a-vinduer.dk
|
Finn Poulsen
|
Nybølle
|
2026-03-02 |
ok
|
|
—
|
ramgaard.dk
|
Jette Ramgaard
|
Smørumnedre
|
2026-03-02 |
err
|
|
—
|
baneboeger.dk
|
Datoselskabet af 13. juni 2024 ApS
|
Smørumnedre
|
2026-03-02 |
err
|

|
innovati.dk
|
Jacob Ringgaard
|
Smørumvang
|
2026-03-02 |
ok
|

|
ledoejepc.dk
|
Søren Henrik Lindeløv
|
Ledøje
|
2026-03-02 |
ok
|

|
conlastic.dk
|
ELVERDALS PROF DANISH PRODUCTS A/S
|
Ledøje
|
2026-03-02 |
ok
|

|
soerensmedegaard.dk
|
Søren Smedegaard Hansen
|
Ledøje
|
2026-03-02 |
ok
|

|
subgirl.dk
|
Tania Thrane Ruprecht
|
Ledøje
|
2026-03-02 |
ok
|

|
inframesystems.dk
|
inframe
|
Smørumnedre
|
2026-03-01 |
ok
|

|
montrerpaamaal.dk
|
JOHANNSEN DEKORATION. ISHØJ A/S
|
Lille Smørum
|
2026-03-01 |
ok
|

|
biketravel.dk
|
Kjeld Myhre
|
Lille Smørum
|
2026-03-01 |
ok
|

|
noeddebohave2.dk
|
Gert Karl Nielsen
|
Lille Smørum
|
2026-03-01 |
ok
|

|
smartwork.dk
|
Nicholas Marsner
|
Smørumnedre
|
2026-03-01 |
ok
|

|
larsbechrasmussen.dk
|
Lars Bech Rasmussen
|
Ledøje
|
2026-03-01 |
ok
|

|
mselektronik.dk
|
Michael Schmidt
|
Smørumnedre
|
2026-03-01 |
ok
|

|
toolcycle.dk
|
David Paul Lindhard-Tordrup
|
Smørumnedre
|
2026-03-01 |
ok
|

|
gigt-oplysning.dk
|
Gigtforeningens Oplysningskreds i Ba…
|
Astershaven 263
|
2026-03-01 |
ok
|

|
upcy.dk
|
Textilia Group A/S
|
Kongebakken 1
|
2026-03-01 |
ok
|

|
fugevem.dk
|
Skiklubben Fuge Vem
|
Erantishaven 108
|
2026-03-01 |
ok
|

|
dansknaturgoedning.dk
|
Gunner Larsen & Søn
|
Edelgavevej 5
|
2026-03-01 |
ok
|

|
tsmps.dk
|
Palle Skovgaard
|
Smørumnedre
|
2026-03-01 |
ok
|
|
—
|
frans.dk
|
Frans Saxbeck Larsen
|
Smørumnedre
|
2026-03-01 |
err
|

|
egedalbadogfacade.dk
|
Egedal Bad & Facade ApS
|
Smørumnedre
|
2026-03-01 |
ok
|

|
skatregnskab.dk
|
Arne Pedersen
|
Smørumnedre
|
2026-02-28 |
ok
|

|
flute.dk
|
Niels Michael Ørskov
|
Smørumovre
|
2026-02-28 |
ok
|

|
h-el.dk
|
KAJ RASMUSSEN & SØN, BALLERUP, ApS
|
Smørumovre
|
2026-02-28 |
ok
|

|
gok-ballerup.dk
|
Gigtforeningens Oplysningskreds i Ba…
|
Astershaven 263
|
2026-02-28 |
ok
|

|
aagarden.dk
|
Jan Elvang Hemmingsen
|
Smørumovre
|
2026-02-28 |
ok
|

|
kornerup-fodterapi.dk
|
Christina Aabye Poulsen
|
Smørumnedre
|
2026-02-28 |
ok
|

|
xn--displaypml-85ab.dk
|
JOHANNSEN DEKORATION. ISHØJ A/S
|
Lille Smørum
|
2026-02-28 |
ok
|

|
dybrohansen.dk
|
Allan Hansen
|
Smørumnedre
|
2026-02-28 |
ok
|

|
kennethskourup.dk
|
Kenneth Green Skourup
|
Smørumnedre
|
2026-02-28 |
ok
|

|
svante-amalie.dk
|
Ingrid Kirstine Nielsen
|
Smørumnedre
|
2026-02-28 |
ok
|

|
groentfokus.dk
|
Ole Schmidt Hansen
|
Smørumnedre
|
2026-02-27 |
ok
|

|
penge-guide.dk
|
Getresults
|
Jordbærvangen 4
|
2026-02-27 |
ok
|

|
0011.dk
|
Martin Andreasen Bjørk
|
Smørumnedre
|
2026-02-27 |
ok
|

|
humanassist.dk
|
Anders Krauch
|
Smørumnedre
|
2026-02-27 |
ok
|
|
—
|
xn--videnscenterforseniorkonomi-v0c.dk
|
Ulrik Munk Yde
|
Smørumnedre
|
2026-02-27 |
err
|

|
naturgoedningkbh.dk
|
Gunner Larsen & Søn
|
Edelgavevej 5
|
2026-02-27 |
ok
|

|
rindum.dk
|
Kenneth Rindum
|
Smørumnedre
|
2026-02-27 |
ok
|

|
neckadds.dk
|
Kasper Hougaard Færk
|
Smørumnedre
|
2026-02-27 |
ok
|

|
sugekopper.dk
|
BONDY LMT A/S
|
Lille Smørum
|
2026-02-27 |
ok
|

|
cotedazur-guide.dk
|
WebSights
|
Kong Knuds Park 32
|
2026-02-27 |
ok
|

|
skift-vinduer.dk
|
BRDR. GIMM ApS
|
Lille Smørum
|
2026-02-27 |
ok
|

|
atabdanmark.dk
|
Finn Poulsen
|
Hove
|
2026-02-27 |
ok
|

|
gartnerforsyningen.dk
|
GARTNERFORSYNINGEN BENDT M PYNDT
|
Hove
|
2026-02-27 |
ok
|

|
biosaledanmark.dk
|
BIOSALE DANMARK ApS
|
Smørumnedre
|
2026-02-27 |
ok
|

|
lunna.dk
|
Marianne Lund
|
Lille Smørum
|
2026-02-27 |
ok
|

|
hold-da-fest.dk
|
Tempo Trans
|
Stangkær 1
|
2026-02-26 |
ok
|